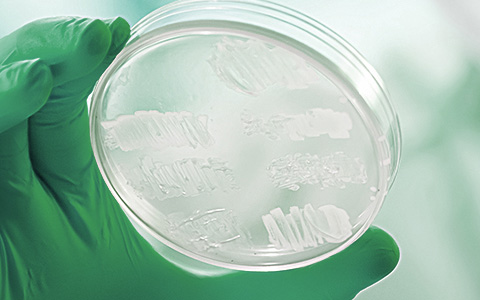
03 - �̻��� ���� ����

01
농업용 제품
인간과 환경에 유익한 미생물로 토양 환경을 개선하여 농작물의 생육 촉진을 돕고 병해충을 감소시켜 친환경 농업을 돕습니다.
About Microsolution
마이크로솔루션
하병덕
2015년 7월
농축산용 제품, 미생물 배양용 배지·

인간과 환경에 유익한 미생물로 토양 환경을 개선하여 농작물의 생육 촉진을 돕고 병해충을 감소시켜 친환경 농업을 돕습니다.

사료비 및 각종 경영비의 절감과 질병예방, 생산성 향상을 통해 소득증대와 안전한 축산물을 확보하기 위해 최선을 다합니다.
효과가 좋은 유용미생물을 배양 및 활용법 등을 연구하여 농·축가에 보급하며 친환경 농·축업 육성과 안전한 먹거리 생산을 위한 기반을 조성합니다.

풍부한 발효 공정 기술과 경험을 바탕으로 농축산용 미생물의 연구개발 및 발효생산 대행을 하고 있습니다.